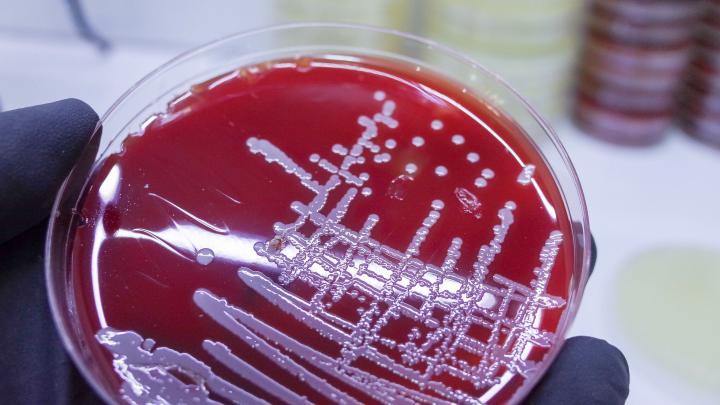

Raport: ponad 3 mln zgonów dzieci na świecie z powodu infekcji opornych na antybiotyki
Kwi 15, 2025 0
Kwi 9, 2025 0
Kwi 16, 2025 0
Kwi 16, 2025 0
Kwi 10, 2025 0
Kwi 16, 2025 0
Lut 17, 2025 0
Lub zarejestruj się za pomocą e-maila
Kwi 19, 2025 0
Kwi 19, 2025 0
Kwi 19, 2025 0
Kwi 19, 2025 0
Kwi 19, 2025 0
Ta strona używa plików cookie. Kontynuując przeglądanie strony, wyrażasz zgodę na korzystanie z plików cookie